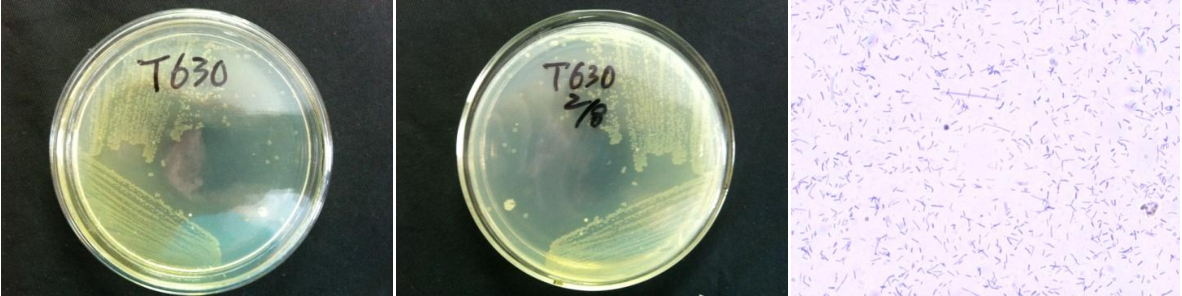

Loading...
| StrainNO | B466 |
| Classification | Pseudomonas |
| 16s rDNA sequence | CTGGAGCAACCCACTCCCATGGTGTGACGGGCGGTGTGTACAAGGCCCGGGAACGTATTCACCGTGACATTCTGATTCACGATT ACTAGCGATTCCGACTTCACGCAGTCGAGTTGCAGACTGCGATCCGGACTACGATCGGTTTTATGGGATTAGCTCCACCTCGCG GCTTGGCAACCCTTTGTACCGACCATTGTAGCACGTGTGTAGCCCAGGCCGTAAGGGCCATGATGACTTGACGTCATCCCCACC TTCCTCCGGTTTGTCACCGGCAGTCTCCTTAGAGTGCCCACCATAACGTGCTGGTAACTAAGGACAAGGGTTGCGCTCGTTACG GGACTTAACCCAACATCTCACGACACGAGCTGACGACAGCCATGCAGCACCTGTGTCTGAGTTCCCGAAGGCACCCCGCCATCT CTGGCAGGTTCTCAGCATGTCAAGGCCTGGTAAGGTTCTTCGCGTTGCTTCGAATTAAACCACATGCTCCACCGCTTGTGCGGG CCCCCGTCAATTCATTTGAGTTTTAACCTTGCGGCCGTACTCCCCAGGCGGTCGACTTAATGCGTTAGCTGCGCCACTAAGATC TCAAGGATCCCAACGGCTAGTCGACATCGTTTACGGCGTGGACTACCAGGGTATCTAATCCTGTTTGCTCCCCACGCTTTCGCA CCTCAGTGTCAGTATTAGCCCAGGTGGTCGCCTTCGCCACTGGTGTTCCTTCCTATATCTACGCATTTCACCGCTACACAGGAA ATTCCACCACCCTCTGCCATACTCTAGCTTGCCAGTTTTGGATGCAGTTCCCAGGTTGAGCCCGGGGCTTTCACATCCAACTTA ACAAACCACCTACGCGCGCTTTACGCCCAGTAATTCCGATTAACGCTTGCACCCTTCGTATTACCGCGGCTGCTGGCACGAAGT TAGCCGGTGCTTATTCTGTCGGTAACGTCAAAACACTAACGTATTAGGTTAATGCCCTTCCTCCCAACTTAAAGTGCTTTACAA TCCGAAGACCTTCTTCACACACGCGGCATGGCTGGATCAGGCTTTCGCCCATTGTCCAATATTCCCCACTGCTGCCTCCCGTAG GAGTCTGGACCGTGTCTCAGTTCCAGTGTGACTGATCATCCTCTCAGACCAGTTACGGATCGTCGCCTTGGTGAGCCATTACCT CACCAACTAGCTAATCCGACCTAGGCTCATCTGATAGCGCAAGGCCCGAAGGTCCCCTGCTTTCTCCCGTAGGACGTATGCGGT ATTAGCGTTCCTTTCGAAACGTTGTCCCCCACTATCAGGCAGATTCCTAGGCATTACTCACCCGTCCGCCGCTGAATCCAGGAG CAAGCTCCCTTCATCCGCTCGACTGCCATGGTAGGCCTGCCCCCC |
| Strain Morphology Photos | |
| Morphological Description | Colony round;pale yellow;steam bun shaped;edge neatly;bright;sticky;Bacteria Body Rod-shaped;no spore |